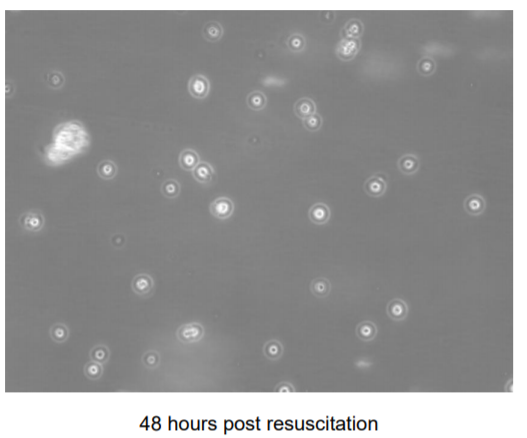
ECACC RPMI 8866细胞

万千商家帮你免费找货
0 人在求购买到急需产品
- 详细信息
- 询价记录
- 文献和实验
- 技术资料
- 品系:
Human B lymphocyte
- 细胞类型:
Lymphoblastoid
- 肿瘤类型:
咨询
- 供应商:
北京孚博
- 库存:
100
- 英文名:
RPMI 8866 cell line
- 生长状态:
Suspension
- 年限:
咨询
- 运输方式:
干冰、液氮
- 器官来源:
咨询
- 是否是肿瘤细胞:
否
- 细胞形态:
咨询
- 免疫类型:
咨询
- 物种来源:
人
- 相关疾病:
咨询
- 组织来源:
血液
- 规格:
1支
ECACC 成立于 1985 年,是一家为研究界提供服务的细胞培养收集机构,并为欧洲提供国际保藏机构认可的专利保藏机构。
如此多样化的馆藏的开发和维护不可避免地产生了高水平的专业知识,再加上英国公共卫生部门的支持,使 ECACC 能够将自己定位为细胞培养各个方面的专业知识中心。
我们提供全面的细胞培养服务,包括细胞系认证和培训课程,并多元化进入新产品领域,例如从细胞系和 iPSC 中提取的高质量基因组 DNA。
以国内使用较多的细胞系#95041316,RPMI 8866 为例,产品详情如下:
ECACC General Cell Collection: RPMI 8866
| Supplied by: | European Collection of Authenticated Cell Cultures (ECACC) |
| Culture Type: | Cell line |
| Collection: | ECACC General Collection |
| Catalogue No.: | 95041316 |
| Cell Line Name: | RPMI 8866 |
| Citation Guidance: | If use of this culture results in a scientific publication, it should be cited in the publication as: RPMI 8866 (ECACC 95041316) |
| Keywords: | Human B lymphocyte |
| Cell Line Description: | RPMI 8866 has been established from the peripheral blood of a 51-year-old American woman with chronic myelogenous leukaemia in May 1966. The B lymphoid cell line expresses a relatively high amount of calcitonin receptors, membrane bound Ig and soluble IgE-binding factor (Fc epsilon RII/CD23). |
| Species: | Human |
| Tissue of Origin: | blood |
| CellType: | Lymphoblastoid |
| Growth Mode: | Suspension |
| DNA Profile: | STR-PCR Data: Amelogenin: X CSF1PO: 11 D13S317: 10,14 D16S539: 11 D5S818: 12 D7S820: 11,12 THO1: 9.3 TPOX: 8,11 vWA: 14,16 |
| Karyotype: | Not specified |
| Biosafety Information: | Unless specified otherwise, at the European Collection of Authenticated Cell Cultures (ECACC) we routinely handle all of our cell lines at containment level 2 in accordance with the ACDP guidelines. ACDP = Advisory Committee on Dangerous Pathogens (UK) All cell cultures have the potential to carry as yet unidentified adventitious agents. It is the responsibility of the end user to ensure that their facilities comply with biosafety regulations for their own country. ACDP Guidance: Biological agents: Managing the risks in laboratories and healthcare premises. Hyperlinks to MSDS documents: Frozen cell cultures Material Safety Data Sheet Growing cell cultures Material Safety Data Sheet Nucleic acids derived from cell cultures Material Safety Data Sheet |
| Subculture Routine: | To keep the cells in exponential growth maintain cultures between 3-9x100,000 cells/ml; 5% CO2; 37°C. If starting from a frozen ampoule, add thawed cells to a conical based centrifuge tube e.g. 15ml tube. Slowly add 4 ml of culture medium to the tube. Take a sample of the cell suspension, e.g. 200ul, to count cells. Centrifuge the cell suspension at low speed i.e. 100 - 150 x g for a maximum of 5 minutes. Remove medium and re-suspend the cell pellet at a density of 3 - 5 x 100,000 cells/ml in fresh medium containing 10% serum. Incubate flask at 37 C; 5 - 7% CO2. Check daily. Keep flask in a vertical position until the cells reach the exponential phase of growth, this can take up to 7 days. |
| Culture Medium: | RPMI 1640 + 2mM Glutamine + 10% Foetal Bovine Serum (FBS). |
| Depositor: | Prof G Moore, Colorado Oncology Foundation, Denver General Hospital, Co 80204-4507 |
| Originator: | Yes |
| Country: | USA |
| References: | J Immunol 1967;99:839; J Biol Chem 1974;249:6812 |
| Additional Bibliography: | Not specified |
| Patents: | None specified by Depositor |
| Release Conditions: | No |
细胞图片:

ECACC细胞库中保藏的细胞系类型有:
General Cell Collection
More than 1100 different cell lines originating from over 45 different species and a wide variety of tissues. Search, browse or look through our cell lines grouped according to a particular characteristic or area of study:
Induced Pluripotent Stem Cell (iPSC) Lines
A range of human induced pluripotent stem cell (iPSC) lines derived from individuals with a known disease status or described as normal for use as controls. The cell lines available are distributed by ECACC on behalf of the European Bank of induced pluripotent Stem Cells (EBiSC) or the Human Induced Pluripotent Stem Cells Initiative (HipSci).
SCREENflex GPCR Cell Lines
A range of G-protein coupled receptor (GPCR) cell lines available as single seed vials or as Frozen, Assay Ready reagent.
Hybridoma Collection
Over 400 monoclonal antibody-secreting hybridomas with a diverse range of antigen specificities.
Chromosomal Abnormality Collection
A subset of samples from the Human Genetic Collection represented by cell lines (the majority are B-lymphoblastoid cell lines) and peripheral blood leukocyte samples derived from individuals determined to carry chromosomal abnormalities.
HLA-Typed Collection
A specialised collection of over 430 reference B-lymphoblastoid cell lines, originating from laboratories all over the world, for which Human Leukocyte Antigen (HLA) typing data is available.
Human Random Control Collection
A collection of more than 700 B-lymphoblastoid cell lines derived from randomly selected Caucasian blood donors whose parents and grandparents were born in the UK or Ireland.
新细胞系:
| Catalogue number | Cell line name | Keywords |
| 16110902 | N14A | Pseudomyxoma peritonei, PMP, appendicitus, appendiceal origin, appendix |
| 16110903 | N15A | Pseudomyxoma peritonei, PMP, appendicitus, appendiceal origin, appendix |
| Catalogue number | Cell line name | Keywords |
| 17100525 | HeLa mCherry-Histone H2B EGFP-Alpha Tubulin | EGFP, Human Histone H2B, mCherry, Alpha Tubulin, fusion protein, H2B-mCherry, EGFP-Alpha Tubulin |
| Catalogue number | Cell line name | Keywords | |||||||||||||
| 16022517 | MCF7/AnaR-2 | Breast cancer, MCF7, Anastrozole resistance, aromatase inhibitors, ER+ | |||||||||||||
| 16022520 | MCF7/ExeR-1 | Breast cancer, Exemestane resistance, aromatase inhibitor, MCF7, ER+ | |||||||||||||
| 16022521 | MCF7/ExeR-2 | Breast cancer, Exemestane resistance, aromatase inhibitors | |||||||||||||
| 16022522 | MCF7/ExeR-3 | Breast cancer, Exemestane resistance, Aromatase inhibitors | |||||||||||||
| Catalogue number | Cell line name | Keywords | |||||||||||||
| 15121704 | HT29-5FU resistant (1 microMolar) | HT29-5FU, 5-Fluorouracil-resistance, goblet cells, gastric mucins. dome-forming cells, 5FU | |||||||||||||
| 15121705 | HT29-MTX resistant (1 microMolar) | HT29-MTX, methotrexate-resistance, goblet cells, gastric mucins, MTX | |||||||||||||
| 15121709 | HT29-5FU resistant (10 microMolar) | HT29-5FU, 5-Fluorouracil-resistance, goblet cells, gastric mucins, 5FU, 5-fluorouracil, 5-FU | |||||||||||||
| 15121710 | HT29-MTX resistant (100 microMolar) | Colon carcinoma, drug resistance, methotrexate, HT29-MTX, methotrexate-resistance, goblet cells, gastric mucins | |||||||||||||
| 15121711 | HT29-MTX resistant (10 microMolar) | HT29-MTX, methotrexate-resistance, goblet cells, gastric mucins | |||||||||||||
| Catalogue number | Cell line name | Keywords | |||||||||||||
| 19061801 | Rev-Erb alpha (NR1D1) | Nuclear Receptor subfamily 1, group D member 1, (NR1D1), Hynridoma (6F05-2), mouse mAb | |||||||||||||
| Catalogue number | Cell line name | Keywords | |||||||||||||
| 19031501 | KT15 | T cell clone, C6, H-2KK restricted antigen specific CTL, monoclonal antibody, mouse | |||||||||||||
| Catalogue number | Cell line name | Keywords | |||||||||||||
| 19022601 | Aag2-AF5 | Aedes aegypti, clonal cell line | |||||||||||||
| Catalogue number | Cell line name | Keywords | |||||||||||||
| 19022602 | Aag2-AF319 | Aedes aegypti-derived clonal cell line, Dcr2 knockout, RNAi deficiency | |||||||||||||
| Catalogue number | Cell line name | Keywords | |||||||||||||
| 16022503 | MCF7/164R-4 | Breast cancer, fulvestrant resistance, ER alpha | |||||||||||||
| 16022505 | MCF7/164R-7 | Breast cancer | |||||||||||||
| 16022510 | MCF7/TAMR-8 | Breast cancer, tamoxifen-resistant | |||||||||||||
| 16022516 | MCF7/AnaR-1 | Breast cancer, MCF7, Anastrozole resistance | |||||||||||||
| 16022518 | MCF7/AnaR-3 | Breast cancer, MCF7, Anastrozole resistance | |||||||||||||
| 16022525 | MCF7/LetR-2 | Breast cancer, Letrozole resistant | |||||||||||||
| 16022526 | MCF7/LetR-3 | Breast cancer, Letrozole resistant | |||||||||||||
| 16022528 | MCF7/TAMR-4 | Human, Breast, Cancer, Oestrogen receptor, Tamoxifen resistant | |||||||||||||
| Catalogue number | Cell line name | Keywords | |||||||||||||
| 17100230 | SG01 | Subglottic stenosis, cancer, inflammation, immortalised, cell line | |||||||||||||
| Catalogue number | Cell line name | Keywords |
| 17100502 |
Wilms’ Tumor 17.94 | Wilms’ Tumor, cell line, anaplastic |
| Catalogue number | Cell line name | Keywords |
| 17100529 | HeLa EGFP-Histone H2B | PP6 catalytic activity, EGFP, EGFP-tagged histone H2B |
| Catalogue number | Cell line name | Keywords |
| 17100531 | HEK293-A mRFP-ATG9 | Autophagy, Cancer, Cell Signalling, Signal Transduction, Cellular Transport, Drug Discovery & Development, Metabolism |
| 17100532 | HEK293 GFP-WIPI2 | Cancer, neurodegeneration, autophagy |
| 17100533 | HEK293 GFP-WIPI1 | Cancer, neurodegeneration, autophagy |
| Catalogue number | Cell line name | Keywords |
| 17100534 |
CIOV1 | Ovarian cancer, HGSOC |
| CIOV2 | *Not yet available. Coming soon to ECACC* | |
| 17100536 | CIOV3 | High grade serous ovarian cancer, TP53 mutation, BRCA1 and BRCA2 mutations, PTEN, RB1. |
| Catalogue number | Cell line name | Keywords |
| 15121701 | HT29-5F7 | HT29-5F7, 5-fluorouracil and methotrexate-resistance, enterocytic cells, MUC1 mucin |
| 15121702 | HT29-5F12 | HT29-5F12, 5-fluorouracil -resistance, enterocytic cells, MUC2 mucin |
| 15121706 | HT29-5M21 | HT29-5M21, methotrexate-resistance, clone, MUC5AC and MUC5B |
| 15121707 | HT29-5M12 | HT29-5M12, 5-fluorouraci, methotrexate-resistance, clone, mucin, MUC5B |
| Catalogue number | Cell line name | Disease status |
| 77650823 | HPSI1116i-zehh_3 | Rare genetic neurological disorder |
| 77650824 | HPSI1116i-zehh_4 | Rare genetic neurological disorder |
| 77650826 | HPSI1016i-eoxu_2 | Rare genetic neurological disorder |
| 77650827 | HPSI1016i-eoxu_6 | Rare genetic neurological disorder |
| 77650793 | HPSI1016i-livl_2 | Rare genetic neurological disorder |
| 77650794 | HPSI1016i-livl_5 | Rare genetic neurological disorder |
| 77650795 | HPSI1016i-riwg_2 | Rare genetic neurological disorder |
| 77650796 | HPSI1016i-riwg_8 | Rare genetic neurological disorder |
| Catalogue number | Cell line name | Disease Status |
| 77650803 | HPSI1014i-xejd_1 | Normal |
| 77650633 | HPSI0616i-biln_1 | Hereditary spastic paraplegia |
| 77650800 | HPSI0115i-rehy_2 | Normal |
| 77650479 | HPSI0416i-mefc_1 | Usher syndrome and congenital eye defects |
| 77650639 | HPSI0416i-mapx_1 | Alport syndrome |
| 77650542 | HPSI0516i-oadp_5 | Kabuki syndrome |
| 77650653 | HPSI0616i-giql_1 | Bleeding and platelet disorders |
| 77650858 | HPSI0115i-payf_1 | Normal |
| 77650655 | HPSI0616i-gayk_3 | Bleeding and platelet disorders |
| Catalogue number | Cell line name | Keywords |
| 16012201 | C-Raf KI D486A | Knock in, oncogenic mutant |
| 16012205 | MEF Raf1 FF/FF KI | Knock-in, FF/FF Raf1 (Y340F-Y341F) mutant, inactivation |
| 16012209 | MEF RAF1 KO | Knock-out, RAF1, mutant, inactivation |
| Catalogue number | Cell line name | Keywords |
| 16022507 | T47D-182R1 | Breast cancer, fulvestrant resistant |
| 16022508 | T47D-182R2 | Breast cancer, fulvestrant resistant |
| 16022510 | MCF7/TAMR-8 | see December 2020 |
| 16022511 | T47D/S5 | Breast cancer, control for fulvestrant-resistant T47D cell lines |
| 16022528 | MCF7/TAMR-4 | see December 2020 |
| 16022516 | MCF7/AnaR-1 | see December 2020 |
| 16022518 | MCF7/AnaR-3 | see December 2020 |
| 16022520 | MCF7/ExeR-1 | see December 2020 |
| 16022522 | MCF7/ExeR-3 | see December 2020 |
| 16022526 | MCF7/LetR-3 | see December 2020 |
| Catalogue number | Cell line name | Keywords |
| 17011201 | 17011201 HCT 116 p300 KO [D10] | p300 Knock-Out, colon carcinoma model, HCT 116, p53-dependent apoptosis, cellular adhesion and migration |
| 17011211 | HCT 116 p300 KO Rescue | p300 Knock-Out, colon carcinoma model, HCT 116, p53-dependent apoptosis, cellular adhesion and migration |
| 17011214 | HCT 116 p300 WT | p300 Knock-Out,colon carcinoma model, HCT 116, p53-dependent apoptosis, cellular adhesion and migration |
| 17011215 | HCT 116 p300 KO [F2] | p300 Knock-Out,colon carcinoma model, HCT 116, p53-dependent apoptosis, cellular adhesion and migration |
| 17011216 | HCT 116 p300 KO [F5] | p300 Knock-Out,colon carcinoma model, HCT 116, p53-dependent apoptosis, cellular adhesion and migration |
| Catalogue No. | Cell Line Name | Keywords |
| 16022512 | T47D/S2 | Human, Breast, Cancer, Oestrogen receptor |
| 16022509 | MCF7/TAMR-7 | Breast cancer, tamoxifen-resistant |
| 16022513 | T47D/TR-1 | Breast carcinoma, tamoxifen resistant, oestrogen receptor |
| 16022523 | MCF7/ExeR-4 | Breast cancer, Exemestane resistance |
| 16022524 | MCF7/LetR-1 | Breast cancer, Letrozole resistant |
| 16022519 | MCF7/AnaR-4 | Breast cancer, MCF7, Anastrozole resistance |
| 16022501 | MCF7/S0.5 | Human, Breast, Cancer, Oestrogen receptor, MCF7 |
| 16022506 | MCF7/182R-6 | Breast cancer, fulvestrant resistant |
| Catalogue number | Cell line name | Keywords |
| 15042901 | CHO-K1.Cl6 | CHO-K1, FcγRIIIa , Fc gamma receptor 3A, 158V, allotype, human IgG , IgG binding |
| 15042902 | CHO-K1.Cl7 | CHO-K1, FcγRIIIa , Fc gamma receptor 3A, 158F, allotype, human IgG , IgG binding |
| 15042903 | CHO-K1.Cl-0204 | CHO-K1, FcγRIIa , Fc gamma receptor 2A, 131R, allotype |
| 15042905 | CHO-K1.Cl-0205 | CHO-K1, FcγRIIa , Fc gamma receptor 2A, 131H, allotype, human IgG , IgG binding |
| 15042907 | CHO-K1.Cl-0206 | CHO-K1, FcγRIIb , Fc gamma receptor 2b |
| 15042908 | CHO-K1.Cl-0235 | CHO-K1, non-human primate FcγRIIIa , Fc gamma receptor 3A, Pan troglodytes, chimpanzee |
| 15042909 | CHO-K1.Cl-0236 / CHO-K1.Cl-0239 | CHO-K1, non-human primate FcγRIIIa , Fc gamma receptor 3A, Cercocebus torquatus, red-crowned mangabey, papio anubis, olive baboon |
| 15042910 | CHO-K1.Cl-0237 | CHO-K1, non-human primate FcγRIIIa , Fc gamma receptor 3A, Macaca fascicularis (Cynomolgus macaque) |
| 15042911 | CHO-K1.Cl-0238 | CHO-K1, non-human primate FcγRIIIa , Fc gamma receptor 3A, Macaca mulatta (Rhesus macaque) |
| 15042912 | CHO-K1.Cl-0270 | CHO-K1, non-human primate FcγRIIb , Fc gamma receptor 2b, Macaca mulatta, Rhesus macaque, Macaca fascicularis, Cynomolgus macaque |
| Catalogue No. | Cell line name | ULK 1 and 2 status | Immortalisation method |
| 14050808 | ULK1/2 WT MEF (SIM) | Wild type | Spontaneously immortalised |
| 14050804 | ULK1/2 WT MEF (SV40) | Wild type | SV40-immortalised |
| 14050806 | ULK1 KO MEF (SIM) | ULK1 knock-out | Spontaneously immortalised |
| 14050807 | ULK1 KO MEF (SV40) | ULK1 knock-out | SV40-immortalised |
| 14050810 | ULK2 KO MEF (SIM) | ULK2 knock-out | Spontaneously immortalised |
| 14050805 | ULK2 KO MEF (SV40) | ULK2 knock-out | SV40-immortalised |
| 14050803 | MEF Ulk1 -/- Ulk2 -/- (DKO) (SIM) | Double knock-out | Spontaneously immortalised |
| 14050802 | MEF Ulk1 -/- Ulk2 -/- (DKO) (SV40) | Double knock-out | SV40-immortalised |




风险提示:丁香通仅作为第三方平台,为商家信息发布提供平台空间。用户咨询产品时请注意保护个人信息及财产安全,合理判断,谨慎选购商品,商家和用户对交易行为负责。对于医疗器械类产品,请先查证核实企业经营资质和医疗器械产品注册证情况。
- 作者
- 内容
- 询问日期
 文献和实验
文献和实验1) 配制培养基最好使用新制备的三蒸水。一般在试验前当天或前一天制备为好。调节pH值的酸碱溶液也应该使用这种水配制。 2) 制备培养基的器皿清洗要绝对干净,烤干后备用(滤器、滤膜、量筒、移液管及盛放培养基的小瓶等存放和转移培养基液体的器具都应进行灭菌)。 3) 溶解培养基:将干粉培养基溶于总量1/3的水中,再用水洗包装袋内面两次,倒入培养液中。振荡
相关专题 细胞培养基的配制 细胞培养专题 MEM细胞培养基 关于RPMI 1640细胞培养 液的配制 1) 配制培养基最好使用新制备的三蒸水。一般在试验前当天或前一天制备为好。调节pH值的酸碱溶液也应该使用这种水配制。 2) 制备培养基的器皿清洗要绝对干净,烤干后备用(滤器 、滤膜、量筒、移液管及盛放培养基的小瓶等存放和转移培养基液体的器具都应进行灭菌)。 3) 溶解培养基:将干粉培养基溶于总量
40 维生素 B 12 0.005 RPMI-1640(A) 无酚红细胞培养基(粉末型)成分
 技术资料
技术资料需要更多技术资料 索取更多技术资料
资料下载:
m219_passage-numbers-explained.pdf 附 (下载 0 次)
image-rpmi-8866-95041316.pdf 附 (下载 0 次)
请 [登录] 后再下载!






